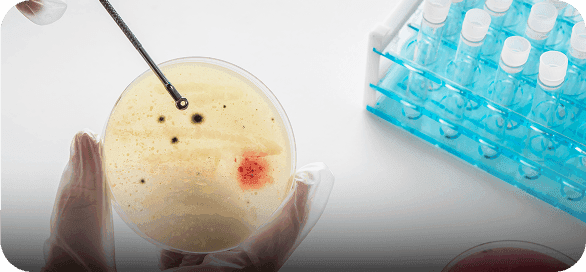
featureCard

About OHVN

About us
About Us
OPEN Healthcare Viet Nam


Our Facilities
With modern equipment and the latest technologies, the diagnostic and treatment process become more accurate and effective.








Home Testing Service – Fast, Safe, Convenient
In Hanoi, OPEN Healthcare Vietnam is one of the pioneers in providing at-home testing services.

Simply book an appointment through the app, and the medical staff will come directly to your location for sample collection.
Users can conveniently access their test results online, saving time and reducing the need for hospital visits.
This solution fits perfectly with a busy lifestyle while also promoting the preventive healthcare model.




Featured Services at OPEN Healthcare Vietnam
Comprehensive STIs and HPV Testing

Early detection of reproductive tract infections to protect reproductive health and community well-being.
Early Cancer Screening

AI-powered analysis and diagnosis of 10 prevalent cancers, improving diagnostic precision and minimizing errors.
Personalized Comprehensive Health Check-up Package

Customized according to personal health status and specific needs.
Mobile App for Scheduling Appointments and Accessing Test Results Online

Efficient, Timely, and Secure
We invest in and implement advanced molecular diagnostic systems – a technology widely applied in South Korea. This technology helps to:
Early detec of infectious diseases, genetic disorders, and potential health risks.

Support healthcare facilities in developing accurate treatment regimens.

Empower individuals to take charge of their health starting from prevention.


Our Commitment to a Healthier Community
Not only focusing on advanced testing services, OPEN Healthcare Vietnam also regularly organizes:


Healthcare Cooperation Programs between Vietnam and Korea

Free or Discounted Testing Programs for the Community

Activities to raise awareness of disease prevention and preventive healthcare.


Global Collaboration and Future Growth Direction
At the opening ceremony, Mr. Chun Jong Kee – Chairman of the Seegene Medical Foundation – emphasized:
“OPEN Healthcare is committed to accompanying Vietnam on its journey to build a modern healthcare system through high-quality, fast, and accurate diagnostic technology.”
OPEN Healthcare Vietnam will continue to:
Transfer advanced diagnostic technology from Korea.
Train high-quality medical professionals.
Expand professional collaboration with healthcare institutions both domestically and internationally.
Its long-term goal is to contribute to making Vietnam a leading country in the healthcare sector, moving toward a sustainable, modern, and diverse healthcare system.
Our Doctor
It’s Our Skilled Experts Who Make the Difference at OHVN Diagnostic Laboratory